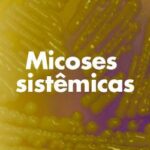

Hoje vou abordar sobre insulina endógena, aquele hormônio super importante que é sintetizado no pâncreas e que responde diretamente pelo metabolismo da glicose. Pois é, antes de iniciar, é bom lembrar que a dosagem desse hormônio é espécie-específica, portanto, fique atento quando for solicitar. Ah, e caso seu objetivo seja avaliação terapêutica em pacientes diabéticos insulinodependentes, o exame solicitado deve ser a insulina exógena, ok?!
Eu recomendo sempre que seja feito associação para mensurações de insulina endógena e glicose.
Para suspeita clínica de diabetes, a insuficiência na secreção de insulina acompanhada de hiperglicemia sugere diabetes mellitus tipo 1, mais comum em cães.
Caso a hiperglicemia venha acompanhada de hiperinsulinemia (estágios mais precoces) ou concentrações normais de insulina, o quadro pode ser creditado à resistência insulínica, que determina diversas manifestações clínicas e doenças, como diabetes mellitus tipo 2 (predominante em gatos), hipertensão e doenças cardiovasculares.
A resistência insulínica pode ocorrer de forma secundária a várias doenças em cães e gatos, por isso, é importante investigar a causa base.
O aumento de peso e a resistência insulínica são os principais fatores de risco para desenvolvimento de síndrome metabólica em felinos.
A síndrome metabólica (SM) é um conjunto complexo de fatores de risco que juntos podem predispor ao desenvolvimento de doenças secundárias.
Em bovinos, a resistência insulínica pode ocorrer durante o período de crescimento fetal, produção de leite e balanço energético negativo.
Ocorre forte influência nas condições metabólicas do pós-parto e parece estar relacionada a concentrações elevadas de ácidos graxos não-esterificados (AGNE).
A elevação dos níveis séricos de insulina endógena combinada com hipoglicemia são achados sugestivos para diagnóstico de insulinoma (considerar também exames de imagem).
Embora essa neoplasia seja incomum em cães e ainda mais rara em gatos, os tumores secretores de insulina são quase sempre malignos e correspondem a 0,4% de todos os tumores primários caninos.
O prognóstico da doença varia de reservado a ruim, com alta taxa de mortalidade.
Já para equinos, uma alta concentração de insulina sérica é um indicador bastante sensível do adenoma pituitário.
Além disso, a dosagem de insulina e glicose associadas podem direcionar a avaliação de síndrome metabólica nesta espécie.
Em outra aplicação interessante, a concentração de insulina endógena também pode variar em quadros endotoxêmicos.
Pode haver uma redução relacionada com mecanismos de contrarregulação endógena entre insulina e glicose (hipoinsulinemia secundária à hipoglicemia) ou também devido à inibição da secreção insulínica pela ação de catecolaminas (epinefrina e norepinefrina).
Em quadros mais graves do processo endotoxêmico, pode-se observar hipersecreção insulínica, responsável por agravar o quadro clínico ao acentuar a hipoglicemia. É importante a avaliação conjunta das concentrações séricas de insulina e glicose para detectar hipersecreção insulínica absoluta e/ou relativa.
Bastante informação, não é?!
Só para concluir, temos disponíveis as dosagens de insulina endógena canina, felina, bovina e equina. Fique à vontade para solicitar mais detalhes sobre o assunto na nossa Assessoria Científica! Será um prazer atendê-lo!
Um abraço,
Dr. Otávio Valério de Carvalho
Diretor Técnico – TECSA Laboratórios